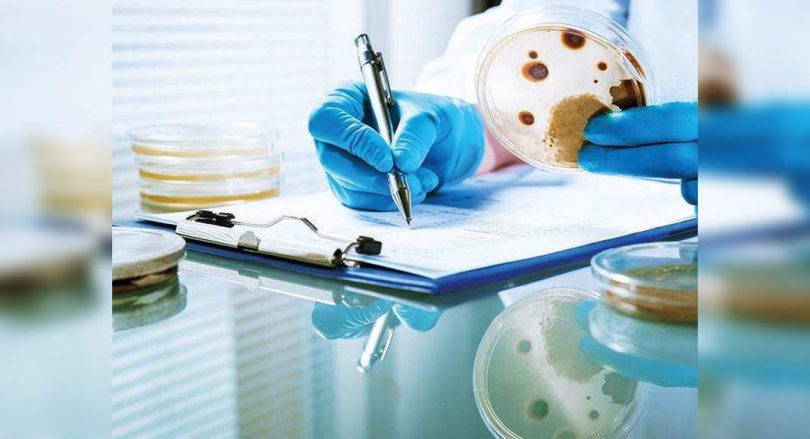
District Pune recorded 69 new cases of fungal infections

Pune: A total of 69 people were diagnosed with Covid (CAM) related mukormycosis in the district last week.
This region now has a total of 1,151 cam cases, detected over the past three months.
Health officials said they saw fewer new cases.
“We reported an average of 120 new cam cases every week for the previous two months.
However, now, weekly improvements have fallen substantially, along with a decrease in Covid-19 cases,” said a health official.
Of the 1,151 patients with cam in the district, 543 underwent treatment, 467 fully recovered and 141 had died.
Invasive fungal infections especially attack sinuses.
Experts say covid patients with diabetes and those who are given steroids during treatment need to be monitored after getting out of the hospital.
“Is diabetes or not, raising blood sugar is the only most important factor in the development of this deadly disease.
So, sugar control is very important,” said the surgeon of Tht Rajeev Yande.
Covid-19 patients who need oxygenation of high flow and drugs such as tovilizumab also need special attention during recovery.
“These patients must be closely monitored and have to undergo diagnostic nose endoscopy,” Yande said.
Certain drugs such as posaconazole and iTraConazole also show positive prophylaxis and early diagnosis remain important for effective treatment.
“Steroid drugs need to be used wisely with expert advice and should be avoided as far as possible in the first week of covid disease with mild symptoms,” Yande said.